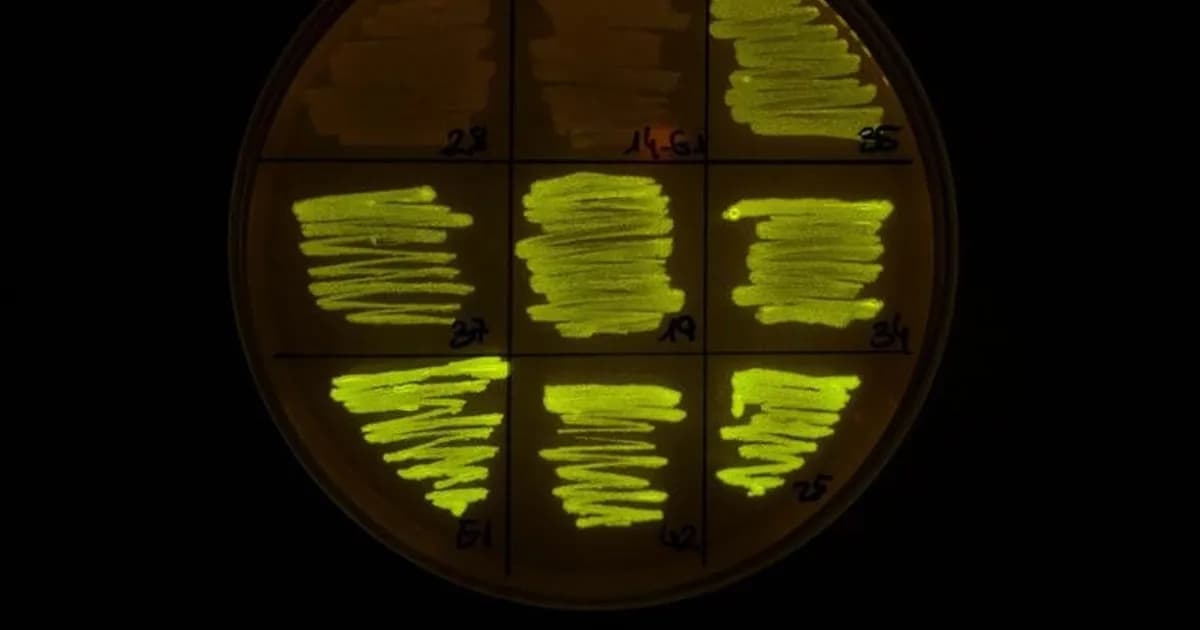
Científicos logran ‘domesticar’ bacteria clave para controlar patógenos vegetales

Google actualiza Chrome para solucionar vulnerabilidades críticas que afectan a varios navegadores
Google lanza una actualización de Chrome para solucionar dos vulnerabilidades críticas que afectan a varios navegadores.
Noticias de tecnología e innovación

Google lanza una actualización de Chrome para solucionar dos vulnerabilidades críticas que afectan a varios navegadores.
Investigadores del CSIC logran 'domesticar' la bacteria Pseudomonas protegens para controlar patógenos en plantas.

Descubrí cómo centros en China entrenan robots humanoides en tareas domésticas con instructores humanos.

La Oficina Europea de Patentes moderniza su proceso de solicitudes con tecnología OCR de Mistral AI.

Las fuerzas israelíes mataron a dos palestinos cerca de Nablús en un nuevo operativo militar, en un contexto de creciente tensión en la región.

Descubrí cómo la regla 10-80-10 de Steve Jobs transformó el liderazgo y la innovación en Apple.

La NASA obtiene imágenes ultravioleta de estrellas fuera del sistema solar, abriendo nuevas posibilidades en la investigación de exoplanetas.

Prosumia avanza en la transformación digital con un enfoque centrado en las personas y la innovación tecnológica.

iPlan se destaca como un gran lugar para trabajar en Argentina, priorizando el bienestar y la innovación en su equipo.

Microsoft lanza 'Xbox Mode', una interfaz que transforma Windows 11 en una experiencia de juego similar a Xbox.

Canal 22 lanza su nueva programación para el 2026, con figuras destacadas y tecnología renovada en su décimo aniversario.

El Indio Solari anuncia un nuevo material a diez años de su emblemático recital en Tandil.